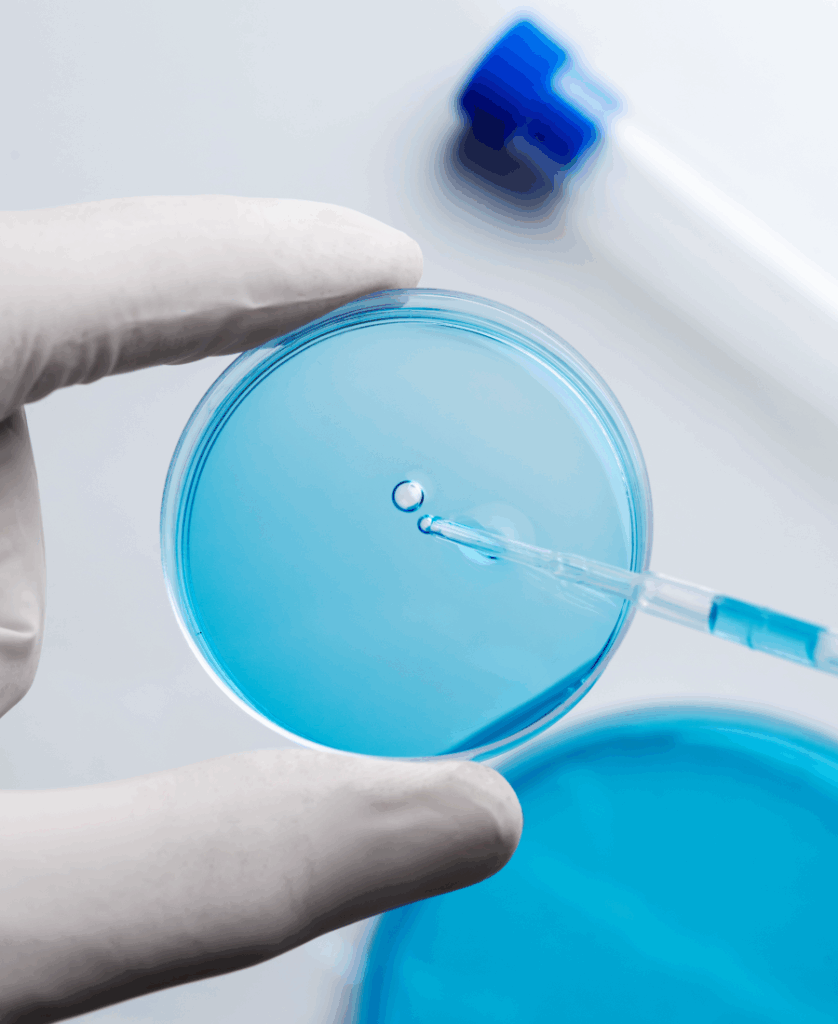

Sterile Formulations Application
Redefining Sterile Manufacturing with Precision Engineering
Precision, purity, and process control — these are the cornerstones of sterile formulation manufacturing. At ELMERC, we specialize in creating sterile process systems that exceed regulatory expectations and ensure complete aseptic integrity across every critical process step.
Meeting the Demands of Sterile Production
Sterile formulations require highly specialized systems capable of handling sensitive ingredients under controlled environments. Our solutions are built with an uncompromising approach to hygiene, contamination control, and regulatory adherence.

Sterile Formulations Application
Complex Injectables
ELMERC systems are tailored for challenging injectable formats, including emulsions, suspensions, and microspheres.
- High-Shear Mixing: Enables homogenous dispersion of APIs and excipients.
- Aseptic Transfer Lines: Fully enclosed to prevent contamination.
- Sterilization-in-Place (SIP): Ensures batch-to-batch sterility.

Sterile Formulations Application
Ophthalmic Preparations
The eyes demand absolute clarity and purity. Our ophthalmic manufacturing systems are designed to eliminate even the smallest particulate risks.
- Low-Shear Agitation: Prevents product foaming or degradation.
- Laminar Air Flow (LAF) Modules: Maintain a clean zone around critical points.
- Automated Cleaning: CIP systems for reduced downtime and operator exposure.
Sterile Formulations Application
Oncology Formulations
Handling cytotoxic and highly potent APIs demands specialized containment and safety.
- Closed Containment Modules: Minimize operator exposure and API loss.
- Deactivation Chambers: For safe handling of waste and residues.
- Validated Cleaning Protocols: To ensure no cross-contamination.

Sterile Formulations Application
Parenteral Drugs
For SVPs and LVPs, our systems ensure accurate dosing, mixing, and sterile delivery.
- Multi-Tank Configurations: Allow flexibility across formulations.
- Volumetric & Gravimetric Dosing: For precise API addition.
- Auto Batch Reporting: Electronic batch manufacturing records (eBMR).

Sterile Formulations Application
Respiratory Medications
Metered-dose and nebulizer-based drugs need careful formulation and precise particle control.
- Vacuum Mixing Systems: To avoid air entrapment.
- Pressurized Filling Units: Safe handling of propellants and volatile ingredients.
- Microbial Filtration: Terminal filtration to remove bioburden.